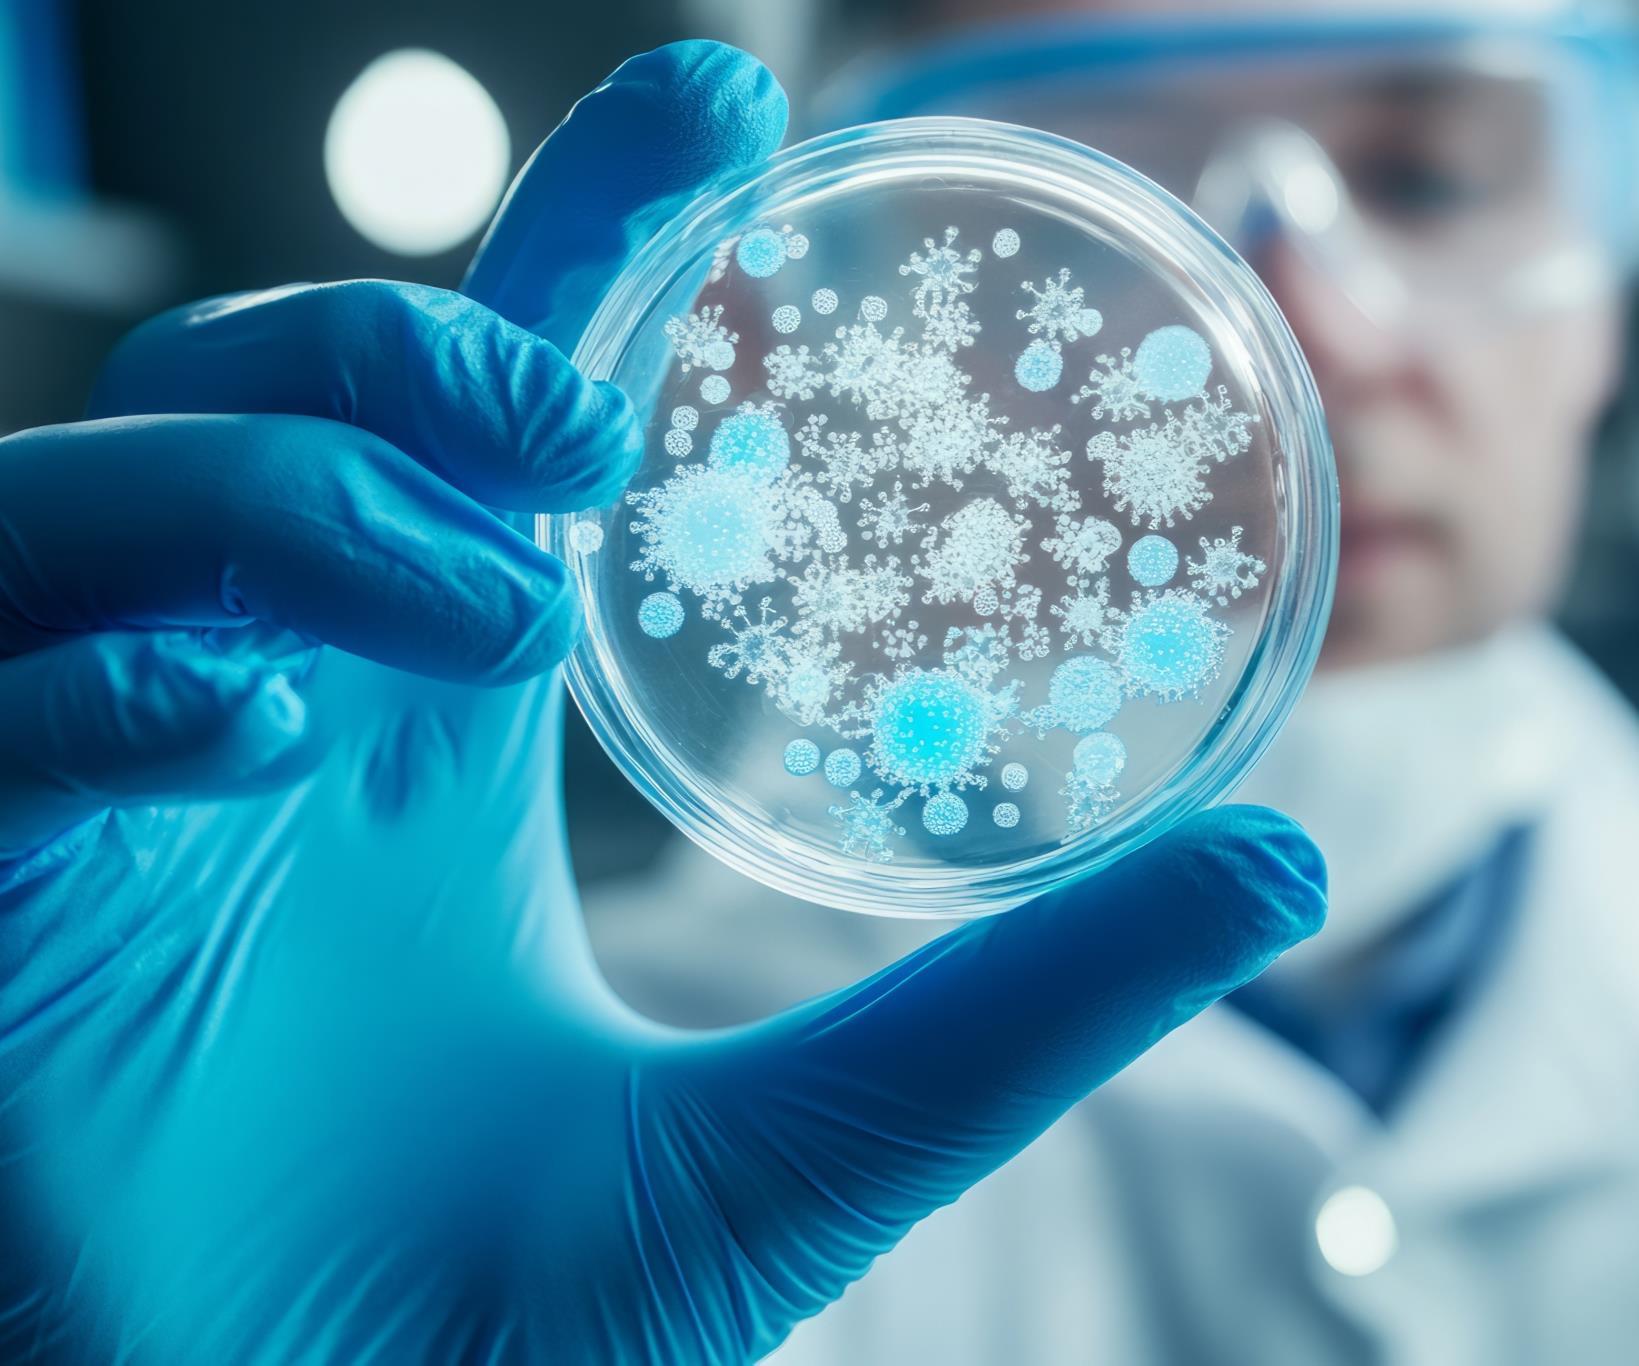

![]()
































Koelnmesse is the leading organiser of supplier trade fairs for the food and beverage industry all over the world including Cologne, Italy, India, China and Colombia. The markets in these countries and thus also the Koelnmesse events held there, offer enormous market potential and growth opportunities for your products and solutions for the food and beverage industry.


Anuga FoodTec
23–26 February 2027 Cologne, Germany


ISM Ingredients ProSweets Cologne
01–04 February 2026 Cologne, Germany
01–04 February 2026 Cologne, Germany

Cibus Tec
27–30 October 2026 Parma, Italy


Cibus Tec Forum Labotec
28–29 October 2025 Parma, Italy
28–29 October 2025 Parma, Italy


Anuga FoodTec India
29 Sept – 01 Oct 2026
Mumbai, India


Anuga FoodTec IndiaDairy Andina Pack
22–24 April 2026
New Delhi, India

Anuga FoodTec China Showcase
27–29 April 2026
Shenzhen, China

LogiMAT & LogiFOOD Southeast Asia
15–17 October 2025
Bangkok, Thailand
04–07 November 2025 Bogotá, Colombia

The internationalsupplier fair for the foodand beverage industry
Date Venue
23-26 February 2027, Triennial
Koelnmesse Exhibition Centre, Cologne, Germany
As the world's leading information and procurement platform, Anuga FoodTec combines all technological solutions along the entire value chain - and that for all sectors of the food and beverage industry. As a trendsetter and leader, Anuga FoodTec offers all cross-process future technologies and enables Industry 4.0 to be experienced in the food and beverage industry.
Number of visitors +40,000 FROM 133 COUNTRIES
Number of exhibitors +1,300 FROM 46 COUNTRIES
ORGANIZED BY

Sources: Worldometer 2025, Statista
Anuga FoodTecis the leadinginternational trade fair forthe foodand beverage industry,, offering end-to-endsolutions for processing, packaging, and storage, with live demonstrations and direct access to manufacturer expertise.
It’s alsoa key platform fordiscovering innovationsand futuretrends like sustainable production, alternative proteins, and new energysolutions helping businesses stay competitive in arapidly evolving market.
Food










Visitors experience holistic process solutions, from safety and digitalization to intralogistics and environmental technology, with live demonstrations of machinery and equipment









The International Ingredients Platformfor Sweets & Snacks
Date Venue
01-04 February 2026, Annual Koelnmesse Exhibition Centre, Cologne, Germany
ISM Ingredients combines the international confectionery trade fair ISM and the supplier trade fair ProSweets Cologne to promote innovation and sustainable production in the confectionery and snack industry.
Number of visitors +32,000 FROM
Number of exhibitors +1,500 FROM 70 COUNTRIES Top
Source: ISM 2025
ORGANIZED



~ 84 million ~ 64 million 19th
Most populous country in the world
Innovationstartswith the ingredient - findthe raw materials of tomorrowat ISM Ingredients - the newplatformfor suppliersof raw materials, ingredientsand semi-finished products.
Right atthe heartof the world'sleading trade fair for confectioneryandsnacks, ISM, a new format willbe createdfrom2026 thatwill enrich the entire industry.
Sources: Worldometer 2025, Statista
Due to rising raw material prices and global challenges, ISM Ingredients puts the spotlight on raw materials & ingredients. The trade fair maximizes synergies between raw material suppliers and manufacturers and strengthens the entire value chain..

Manufacturers of confectionery, chocolate, bakedgoods and snacks

confectionery andsnack industry

Supply chain employees

Research & Development


Sales andMarketing C-levelGroup



Purchasing and procurement managers

Quality Assurance& SustainabiltyOfficers

Managing directors of SMEs

Producers of cocoa,nuts, oilseedsand other raw materials


Producers of flavourings, sweeteners, colourings and functionaladditives


Suppliersoftexturisers, emulsifiersand stabilisers


Suppliersofinnovative, sustainable and alternative rawmaterials

Trade magazines, associations

The internationalsupplier fair for the sweets and snacks industry
Date Venue
01-04 February 2026, Annual Koelnmesse Exhibition Centre, Cologne, Germany
ProSweets Cologne bundles the entire industry know-how of the international supplier sector for the sweets and snacks industry. It shows solutions for all process steps, materials and possible questions simultaneously in the scope of one trade fair platform. ProSweets Cologne is the leading international trade fair of experts for experts. With its unique worldwide offering and its clear structure, ProSweets Cologne offers an overview and prospects for the successful business of the future
Number of visitors +16,000 FROM 85 COUNTRIES
Number of exhibitors +250 FROM 32 COUNTRIES



ProSweetsCologne 2026 is the ideal platformforsupplierstopresent their productsand solutions to international businessesinthe sweetsand snacks industry.
Together with the renowned sweets and snacks trade fair ISM Cologne, ProSweets Cologne represents the entire value chain of the sweets and snacks industry. Every year at ProSweets Cologne, decisionmakers of the sweets and snacks industry from
Managers of the Sweets & Snacks Industry


Research & Development

Purchasing Sales andMarketing



Machines& Equipment


Most populous country in the world
Sources: Worldometer 2025, Statista
all around the world make their rounds. Exhibitors from past trade fairs value our highquality trade visitors of which 89% are involved in procurement decisions and one third have decisive influence in procurement decisions.

Designers

Packaging Designers

ProductManagement & Development

Purchasing Quality Management& Maintenance Automation, Robots,






India’sGlobalGatewayToCutting-Edge TechnologyFortheFood &BeverageIndustry
Date Venue
29 Sept- 01 Oct 2026, Annual Bombay Exhibition Centre, Mumbai, India
Anuga FoodTec India, is India’s leading supplier trade fair for the food and beverage industry. As hub for cutting-edge technologies, key partnerships, and unmatched business opportunities, it has also become a vital sourcing platform for companies across India and neighboring countries.
Number of visitors


Sources: Worldometer 2025, Statista
The Food& Beverage market in Indiais the sixth-largestin the world India’sfood processing sector‘s output is expected to reach $535 by2025-26.
The Packaging Industry in India is expected to register a CAGR of approximately 26.7% during the period (2021-2026). The Indian packaging industry currently provides about 6-7% of the total value available within the global packaging industry.










Mumbai, India's financial hub, offers a dynamic environment for international business and trade, with a strategic location, world-class infrastructure, and a vibrant economy, making it an ideal destination for global enterprises.









Date Venue
22-24 April 2026, Annual Bharat Mandapam, New Delhi, India
India’s premier B2B trade show focused exclusively on dairy technology and innovation. As the leading platform for the entire dairy value chain, it brings together technology providers, dairy processors, cooperatives, private dairies, and government bodies driving progress, partnerships, and the future of dairy in India.

ORGANIZED BY

India is the world’s largest milkproducer, contributing over25% of globaloutput. The dairy industryisvaluedatINR 16,792.1 billion in 2023and projected to reachINR 49,953.5 billion by 2032.
This growth is driven by rising disposable incomes, increased health consciousness, and a surge in demand for value-added products like cheese, curd, and butter. As consumer preferences evolve, there is a growing emphasis on hygienically processed, traceable, and export-ready dairy products.
Dairy Processors Packaged Product Manufacturers

Research & Development and QAHeads


DairyCooperatives, Unions & Federations

Supply Chain, Logistics, andProcurement Professionals




Sources: Worldometer 2025, Statista
Anuga FoodTec India Dairy 2026 serves as the ideal platform for technology providers and stakeholders to come together, explore solutions, and drive the future of India’s rapidly transforming dairy sector.

Private Dairy Companiesand Milk ProcurementUnits

Key DecisionMakers inMarketing and Sales

Exporters, Dealers& Distributors



International ProcessingandPackaging exhibition for the Food, Beverage,PharmaandCosmeticIndustries
Date
Venue
04-07 November 2025, Biennial
Corferias Centro de Negocios y Exposiciones, Bogotá,Colombia
Andina Pack is the leading trade fair for the food and beverage processing, pharmaceutical and cosmetic industries, offering innovative solutions, advanced technologies, packaging, wrapping, printing and labeling for the market in the Andean region
Number of visitors



Sources: Worldometer 2025, Statista
Colombia offers a geographically preferred locationasthe trade-hubtothe AndeanRegion andas abridge between Central andSouthAmerica.
According to Food Export, Colombia‘s processed food exports reached USD 5.6 billion in 2023, positioning the country as the fifth-largest packaged food market in the region.
Conversion & Packaging Managers

Unions & Associations

Research institutes


Distributors for Packaging Food, Cosmetices& Medicines
Packaging Wholesale

Most populous country in the world
AGE COLOMBIAS'S GROSS DOMESTIC PRODUCT (GDP) IN 2023 $363,5 billion USD ~ 32,5 years
The country’s location allows strategic access to the entire Latin American as well as the Caribbean market.
As part of the Pacific Alliance Colombia is your gateway to the markets in Mexico, Peru and Chile

PetFoodIndustry


End Users of Vertical Markets
MaterialHandling Companies Sustainable Technology Consultants

Food& Beverage Processing


Packaging & Wrapping Technology







Innovations for globaltrendsinfood andbeverage technologies
Date Venue
27-30 October 2026, Triennial Fiere di Parma, Parma, Italy
Cibus Tec in Parma, Italy, represents the entire spectrum of the manufacturing industry, from ingredients to process technology, from packaging to logistics. The fair includes exhibition, live presentation, consulting service and workshops and offers the largest hosted buyers programme compared to other supplier fairs for the food and beverage industry.
Number of visitors
+40,00 FROM 122 COUNTRIES
Number of exhibitors
+1,200 FROM 32 COUNTRIES



Parmahosts1,200 foodcompanies, and approximately 60% of the Italian foodindustriesare located withinjust 200 kilometers of Parma.
In the first half of 2022, Italy exported Food & Beverage technologies with a value of 1,722 million euros, and a year-onyear trend variation of +7.8%, confirming its position as the world’s largest exporter in the sector.
Food& Beverage Industry Professionals

Technologysts



Most populous country in the world
Sources: Worldometer 2025, Statista
Nestled in a strategically central location amidst the bustling cities of Northern Italy, Fiere di Parma exhibition center is readily accessible via all major transportation modes With a sprawling exhibition space spanning 140,000 sqm, Fiere di Parma serves as the epicenter of Italy’s industrial activity

Agentsand Distributors PetFoodProfessionals Technology Sollution Manufacturers


Suppliersof Exhibitors


FoodRetailers& Enterpreneurs Students Out of









Exhibition and Conferenceon Food &Beverage TechnologyTrends
Date Venue
28-29 October 2025, Triennial Fiere di Parma, Parma, Italy
Cibus Tec Forum is an unmissable Exhibition-Conference dedicated to the food and beverage technology sector able to combine in just two days the discovery of the most innovative solutions and the most influencing trends that will impact our future habits.
Number of visitors +2,000 FROM 46 COUNTRIES
Number of Exhibitors and sponsors
ORGANIZED



Parmahosts1,200 foodcompanies, and approximately 60% of the Italian foodindustriesare located withinjust 200 kilometers of Parma.
In the first half of 2022, Italy exported Food & Beverage technologies with a value of 1,722 million euros, and a year-onyear trend variation of +7.8%, confirming its position as the world’s largest exporter in the sector.
Food& Beverage Industry Professionals

Technologysts



Most populous country in the world
Sources: Worldometer 2025, Statista
Nestled in a strategically central location amidst the bustling cities of Northern Italy, Fiere di Parma exhibition center is readily accessible via all major transportation modes With a sprawling exhibition space spanning 140,000 sqm, Fiere di Parma serves as the epicenter of Italy’s industrial activity

Agentsand Distributors PetFoodProfessionals Technology Sollution Manufacturers


Suppliersof Exhibitors


FoodRetailers& Enterpreneurs Students Out of
Processing









Date Venue
27-30 October 2026, Triennial Fiere di Parma, Parma, Italy
Labotec is the new exhibition focused on laboratory and analysis, able to combine in just two days the discovery of the most innovative solutions and the most influencing trends. It features networking events, interactive sessions, and B2B meetings designed to foster collaboration.

Parmahosts1,200 foodcompanies, and approximately 60% of the Italian foodindustriesare located withinjust 200 kilometers of Parma.
In the first half of 2022, Italy exported Food & Beverage technologies with a value of 1,722 million euros, and a year-on-year trend variation of +7.8%, confirming its position as the world’s largest exporter in the sector.
Food& Beverage Industry Professionals

Technologysts



Most populous country in the world
Sources: Worldometer 2025, Statista
Nestled in a strategically central location amidst the bustling cities of Northern Italy, Fiere di Parma exhibition center is readily accessible via all major transportation modes With a sprawling exhibition space spanning 140,000 sqm, Fiere di Parma serves as the epicenter of Italy’s industrial activity

Agentsand Distributors PetFoodProfessionals Technology Sollution Manufacturers


Suppliersof Exhibitors


FoodRetailers& Enterpreneurs Students Out of

Processing From Packaging to Logistics Bottling andFilling








Taste the Globe,Capture the Future Southern China's F&B market awaitsyou
Date Venue
27 29 April 2026, Annual Shenzhen Convention & Exhibition Center, Shenzhen, China
With a focus on Packaging, Food Safety and Beverage Technologies, the Anuga FoodTec China Showcase demonstrates the integrity of the production and processing chain, as well as cutting-edge solutions that appeal to consumers while meeting the industry’s sustainability goals.
Number of visitors +31,000 FROM 52 COUNTRIES
Number of exhibitors
ORGANIZED


With the GreaterBay Area's F&B industry projected togrow ata 6% CAGR by2025 and China's food packaging industry reaching US$75billion, this showcase is yourgatewaytocutting-edge solutions in Packaging, Food Safety, and Beverage Technologies.
The total population of the Guangdong-Hong Kong-Macao Greater Bay Area is about 87 million, with the region’s GDP in 2023 exceeding US$ 1.9 trillion

Sources: Worldometer 2025, Statista
Unparalleled synergy in expertise and quality: Benefit from the unique expertise and high standards of Anuga and Anuga FoodTec, the world’s leading industry events

Food& Beverage Producers Supply Chain Professionals Importers of




FoodRetailers Intralogistics








The premiertrade showfor foodlogistics andcoldchainsolutions
Date Venue
15-17 October 2025, Annual Bangkok International Trade & Exhibition Centre BITEC, Bangkok, Thailand
LogiFOOD Southeast Asia is a platform for showcasing cutting-edge food storage equipment, state-of-the-art refrigeration systems, streamlined processing techniques, and sustainable packaging solutions. Taking place at the same time as LogiMAT Southeast Asia, which focuses on intralogistics solutions and process management, the international fair offers innovative solutions for food logistics, cold chain management, temperature-controlled warehousing, and transportation, redefining the entire supply chain – from factory to consumer.
Number of visitors +5,500
Number of exhibitors

Locatedinthe heartof Bangkok, LogiMAT SoutheastAsia offersanunmatched gateway tothe thriving intralogisticsmarketsacross SoutheastAsia, including Indonesia, Singapore, Malaysia, Vietnam, Myanmar, Laos, andCambodia, and more.
AlongsideLogiMAT, LogiFOOD Southeast Asia offers a crucial accesspointtothe cold chainsupply andfood logistics.
& Beverage Producers

Chemicals

Process Manufacturers






Most populous country in the world
Sources: Worldometer 2025, Statista
Southeast Asia's food and beverageindustry has witnessed a remarkablesurge indemanddueto population growthand increased income.This hasushered inchangesin consumptionpatterns, makingwidespread adoption of temperature-controlledtransportationsystems imperative.












anugafoodtec.com/worldwide